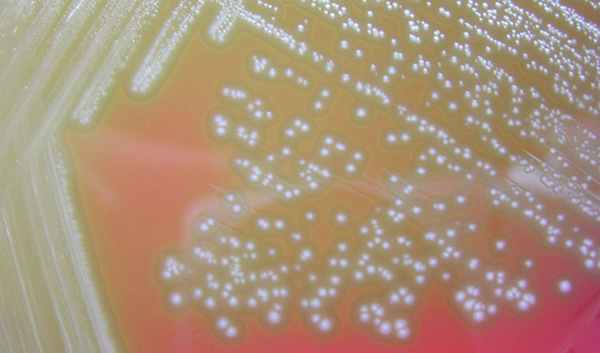
Streptococci viridans

ЭхоКГ диагностика инфекционного эндокардита
Добавил пользователь Morpheus Обновлено: 02.11.2025
Летальность при инфекционном эндокардите (ИЭ) остается высокой (15-25%), несмотря на внедрение в диагностику заболевания эхокардиографии, применение новых антибактериальных препаратов широкого спектра действия, хирургического лечения эндокардита. Худшие результаты лечения отмечаются при остром ИЭ, при котором развиваются тяжелые осложнения, препятствующие оказанию помощи в полном объеме. Примером успешного лечения острого ИЭ может быть следующее клиническое наблюдение. Больной А., 16 лет, поступил в ревматологическое отделение НМХЦ 11.03.08г. с жалобами на повышение температуры тела до 38С, умеренную головную боль в затылочной области ,боль в икроножных мышцах, сердцебиение и выраженную общую слабость. Заболел остро 23.02.08, когда ночью появилась выраженная головная боль в затылочной области на фоне повышения температуры тела до 40,5С. В последующие дни сохранялась лихорадка, появились выраженная слабость, артралгии, миалгии, из-за чего не смог самостоятельно передвигаться. 26.02.08 появились геморрагические высыпания на коже правой стопы, ладонных поверхностях кистей, что в сочетании с упорной головной болью было подозрительно на менингококковый менингит. Скорой помощью госпитализирован в инфекционную больницу с диагнозом менингит.

В ан. крови: гем. 134 г/л, л. 16,1х109/л, СОЭ 21 мм/час. В ан. мочи: белок 0,2 г/л, лейкоцитов 12-17 в п/зр, эритроцитов до 25 п/зр. Посев крови и ликвора от 26.02.08 – роста микрофлоры нет. При исследовании спинномозговой жидкости цитоз 288/3, белок 13 г/л. Учитывая слабо выраженный цитоз, заподозрен вторичный характер менингита, предполагался инфекционный эндокардит. Выполнено ЭхоКГ (06.03.08): вегетации на передней створке митрального клапана. Диагностирован инфекционный эндокардит, назначена антибактериальная терапия ванкомицином 2 г/сут, таваником 1 г/сут. Однако сохранялась лихорадка более 38,0С. В связи с этим 11.03.08 переведен в ревматологическое отделение НМХЦ для дальнейшего лечения. При поступлении состояние средней тяжести. Температура тела при осмотре 37,8 С. На коже правой стопы высыпания по типу геморрагических некрозов кожи. В легких дыхание везикулярное, проводилось во все отделы, хрипов нет, ЧДД 16 в мин. Тоны сердца звучные, на верхушке систолический шум, проводящийся в левую подмышечную область. Живот мягкий, безболезненный, печень выступала из-под края реберной дуги на 2см. Селезенка перкуторно увеличена, не пальпировалась. Ан. крови 12.03.08: гем. 129 г/л, л. 10,4х109/л, п-6%, с – 59%, л – 30%, м – 4%, э-1%, тромбоциты 324 тыс., СОЭ 40 мм/час. Посевы крови и ликвора роста микрофлоры не дали. Исследование ликвора от 12.03: прозрачный, без осадка, белок 0,34 г/л, цитоз 10/3, подтвердило положительную динамику течения менингоэнцефалита. Рентгенологическое исследование органов грудной клетки без патологии. УЗИ органов брюшной полости – увеличение селезенки 13х 6 см.
Трансторокальная ЭхоКГ ( 11.03.08): у основания передней створки митрального клапана со стороны левого предсердия конгломерат вегетаций размером 1,9х1,1 см, митральная регургитация 3 ст.

МРТ головного мозга (11.03.08): в белом веществе головного мозга субкортикально в лобно-теменной области справа определяются округлые и линейные очаги с перифокальным отеком размерами от 3 до 10 мм.

У пациента подтвержден диагноз острого инфекционного эндокардита, недостаточность митрального клапана 3 ст, церебральная эмболия с развитием менингоэнцефалита. Была продолжена терапия ванкомицином и таваником, на фоне которой сохранялась фебрильная лихорадка до 38,5С, в связи с чем проведена смена антибактериальной терапии на линезолид 1,2 г/сут. Однако на фоне терапии сохранялась лихорадка 37,8С. Наличие неконтролируемой инфекции, перенесенная эмболия, наличие крупной вегетации на митральном (наиболее эмбологенном) клапане, явились показанием к протезированию клапана. Осмотрен кардиохирургом. На 7 сутки пребывания в стационаре больному выполнена операция (академиком РАН Шевченко Ю.Л.) санации камер сердца, протезирование митрального клапана протезом Мединдж – 25 в условиях искусственного кровообращения и фармакохолодовой кардиоплегии. Интраоперационно у основания передней створки митрального клапана обнаружен абсцесс диаметром до 1 см. В послеоперационном периоде продолжена терапия ванкомицином 2 г/сут, ципрофлоксацином 0,8 г/сут. На фоне терапии сохранялась лихорадка до 37,9С. В связи с этим пациенту выполнена компьютерная томография органов грудной клетки:
![]() | ![]() |
В средней доле правого легкого массивный участок снижения воздушности легочной ткани с очагами инфильтрации, занимающий практически весь объем доли. Диагностирована госпитальная пневмония в средней доле правого легкого. Учитывая сохраняющуюся лихорадку, проведена смена комбинированной антибактериальной терапии на тиенам 2 г/сут в сочетании с линдацином 2г/сут. Лишь после назначения авелокса 0,4 г/сут с римфапицином 0,6 г/сут достигнута стойкая нормализация температуры тела, исчезновение инфильтративных изменений в легких. Нормализовались лабораторные показатели: гем. – 126 г/л, лейк. 8,1х109/л, п - 1%, с – 38%, СОЭ 12 мм/час. Контрольная чрезпищеводная ЭхоКГ без патологии. В течение последующих 1,5 лет рецидива инфекции не было. Температура тела, ЭхоКГ, лабораторные показатели в норме. Клиническое наблюдение представлено острым по началу инфекционным эндокардитом, при котором летальность приближается к 100%. Антибактериальная терапия как и в нашем наблюдении, редко бывает эффективной. Обычно в ранние сроки, особенно при поражении митрального клапана, развиваются множественные эмболии. Хирургическое лечение должно выполнятся как можно раньше, промедление с операцией могло привести к развитию новых более грозных осложнений, которые могли стать непреодолимым препятствием к хирургическому лечению. Современная оперативная техника позволяет не дожидаться санации клапана антибиотиками, а провести хирургическую санацию очага внутрисердечной инфекции в ранние сроки заболевания при наличии показаний к операции.
© 2022 ФГБУ «НМХЦ им. Н.И. Пирогова» Минздрава России. Использование материалов сайта полностью или частично без письменного разрешения строго запрещено.
ИНФЕКЦИОННЫЙ ЭНДОКАРДИТ
Ведущим критерием диагностики ИЭ является визуализация бактериальных вегетаций. Чувствительность одномерной ЭхоКГ в выявлении бактериальных вегетаций составляет от 13 до 48 %.
Характерным признаком вегетаций является обнаружение грубых, нерегулярных эхо-сигналов на створках клапанов (их называют лохматые,"shaggy"). Этот признак отличается от дрожания створок, обусловленного регургитантным потоком, возникновением в различные фазы систолы и диастолы. Эхо-сигнал от створок значительно усилен, кинетика клапана нарушается в зависимости от особенностей его поражения (стеноз или недостаточность). Следует отметить, что лохматость и утолщенность створок не является высокоспецифичным проявлением для ИЭ. Такие изменения могут наблюдаться при миксоматозном поражении створок (например, пролапс митрального клапана, синдром хлопающего клапана). Значительные трудности в определении признаков ИЭ при одномерной эхокардиографии возникают у больных с кальцификацией и фиброзированием створок. Такие клапаны выглядят толстыми, с нерегулярными вибрациями и лохматыми створками. Диагностические проблемы имеют место у больных с эластофиброзом эндокарда, вследствие врожденных и приобретенных пороков сердца, а также при определении вегетаций на искусственном клапане, особенно в аортальной позиции (возникает выраженный эффект реверберации).
Одномерная эхокардиография позволяет обнаружить только вегетации, превышающие 0,5 см в диаметре. Вновь образующиеся бактериальные вегетации выявляются значительно труднее, чем кальцифицированные.
Чувствительность двухмерной эхокардиографии в выявлении бактериальных вегетаций намного превышает одномерную методику и составляет от 81 до 100%. Наименьший размер клапанных вегетаций, обнаруживаемых с помощью двухмерной эхокардиографии, составляет 2-3 мм. Бактериальные вегетации имеют различную форму, чаще сферическую, плотно фиксированы на клапанных структурах, однако могут быть и подвижные. В последнем случае они перемещаются по направлению потока крови; клинически подтверждаются меняющейся аускультативной симптоматикой, чаще осложняются тромбоэмболическим синдромом. Вегетации могут быть представлены в виде единичного узла, или множественными, в виде гроздьев винограда. Последние отличаются по эхогенности от клапанных структур или поверхности эндокарда, выглядят плотными, имеют эффект реверберации.
Как и при одномерном исследовании эхокардиографические проявления бактериальных вегетаций при секторном сканировании могут имитировать следующие состояния:
- Миксоматозная дегенерация при пролапсе митрального клапана;
- Фиброз или кальцификация вторичные к ревматизму;
- Спонтанный отрыв хорд;
- Узелки на створках при сосудистых коллагеновых заболеваниях.
Ложноотрицательные случаи диагностики наблюдаются при:
- Вегетации менее 2 мм в диаметре;
- Вегетации локализуются на глубине более 7 мм от датчика,
- Эхокардиографическое обследование проведено в первые 2 недели от начала заболевания.
Чреспищеводная эхокардиография в отличии от стандартной методики позволяет выявлять:
- Вегетации при стенозе митрального клапана;
- Вегетации при миксоматозной дегенерации створок;
- Отрыв хорд с вегетациями и без вегетаций;
- Микотические аневризмы с образованием фистул;
- Вегетации на двухстворчатом аортальном клапане;
- Перфорацию створок.
Эхокардиография оказывает существенную помощь в оценке тяжести и прогноза заболевания. Так, установлено, что больные с ИЭ, у которых при обследовании выявляются бактериальные вегетации на митральном клапане чаще имеют проявления декомпенсации кровообращения. При ИЭ аортального клапана, такая взаимосвязь менее выражена, даже при отсутствии вегетаций на клапане заболевание имеет торпидное течение и осложняется рефрактерной сердечной недостаточностью.
Большое значение имеет оценка размера и локализации бактериальных вегетаций. При больших размерах вегетаций прогноз заболевания хуже. Крупные бактериальные вегетации (более 10 мм) чаще обуславливают эмболию. Последняя встречается чаще и при подвижных вегетациях.
Инфекционный эндокардит аортального клапана
ЭхоКГ критерии
Одномерная ЭхоКГ:
- Необычная форма утолщения аортальных створок.
- Нормальная величина открытия аортальных створок.
- Множественные эхосигналы линейного или хаотического характера в просвете аорты в различные фазы сердечного цикла (зависит от положения датчика), реже они могут присутствовать во всех фазах сердечного цикла.
- Нерегулярные, хаотические вибрационные эхосигналы, пролабирующие в левожелудочковый выходной тракт во время диастолы.
- ЭхоКГ-паттерн аортальной недостаточности.
Двухмерная ЭхоКГ:
Инфекционный
эндокардит
аортального клапана,
крупные подвижные
бактериальные
вегетации на
некоронарной створке
в разные фазы
сердечного цикла.
- Непосредственная визуализация клапанных вегетаций на створках с определением их размера, формы и подвижности (чаще поражается правая коронарная створка) (рис. 141 - 142).
- ЭхоКГ-паттерн недостаточности аортального клапана.
Инфекционный
эндокардит
аортального клапана,
вегетации на клапане,
трепетание передней
митральной створки.
Допплер-ЭхоКГ:
Оценка степени недостаточности аортального клапана.
Инфекционный эндокардит митрального клапана
ЭхоКГ критерии
Одномерная ЭхоКГ:
- "Лохматые" эхосигналы от створок митрального клапана, лучше видны во время диастолы ("shaggy").
- ЭхоКГ-паттерн отрыва сухожильных нитей митрального клапана.
- ЭхоКГ-паттерн митральной недостаточности.
Двухмерная ЭхоКГ:
- Дополнительные эхопозитивные массы отходящие от структур митрального клапана более 2 мм.
- Наличие эхопозитивных структур, связанных с митральным клапаном и пролабирующих в левое предсердие (такие подвижные бактериальные вегетации трудно дифференцировать от объемных образований в левом предсердии).
- Наличие эхопозитивных структур на передней створке со стороны левого желудочка в выходном тракте во время систолы (определяются при осложненном течении аортальной недостаточности).
Допплер-ЭхоКГ:
Оценка степени недостаточности митрального клапана.
Дифференциальная диагностика:
- Ревматический вальвулит.
- Наследственные заболевания соединительной ткани.
- Необходимо бактериальные вегетации отличать от альбиниевых узелков (мышечные утолщения свободного края створок, расположены между местами прикрепления к створкам сухожильных хорд - вариант нормального строения клапана), последние обычно не превышают 2 мм в диаметре.
Инфекционный эндокардит трикуспидального клапана
ЭхоКГ критерии
Одномерная ЭхоКГ:
- "Лохматые" (shaggy) эхосигналы от створок трикуспидального клапана.
- ЭхоКГ-паттерн недостаточности трикуспидального клапана.
Двухмерная ЭхоКГ:
- Прямая визуализация эхопозитивных структур, отходящих от клапана (рис.143).
- ЭхоКГ-паттерн недостаточности трикуспидального клапана.
Бактериальный
эндокардит
трикуспидального
клапана: вегетации,
отчодящие от створок
клапана.
Инфекционный эндокардит: проблемы диагностики и лечения
В исследование включены 458 пациентов в возрасте от 12 до 75 лет (средний возраст 49,0±9,3 года) с различными формами инфекционного эндокардита (ИЭ). Ведущим неинвазивным методом предоперационной диагностики заболевания служила комплексная эхокардиография (ЭхоКГ). По данным исследования, чувствительность трансторакальной ЭхоКГ и чреспищеводной ЭхоКГ при первичном ИЭ составила соответственно 96 и 97,9%, при вторичном ИЭ — 59 и 92%, при протезном ИЭ — 2,7 и 90%.Результаты всех ЭхоКГ были верифицированы при интраоперационной ревизии и гистологическом изучении удаленного клапана. При этом не выявлено связи между величиной, локализацией, формой, мобильностью вегетаций и риском развития эмболических осложнений. Комплексная ЭхоКГ обеспечивала формирование правильного диагноза, а также давала возможность принять своевременное решение о необходимости и выборе времени хирургического вмешательства. Основными целями хирургического вмешательства при ИЭ клапанов сердца являются полное удаление/санация инфицированных тканей и восстановление или замена поврежденных клапанов сердца. Общая летальность составила 8,1%. В группе пациентов, оперированных в активной стадии ИЭ, летальность составила 10,5%, в стадии ремиссии — 7,1%. Хирургическое лечение в активной фазе ИЭ показано пациентам с факторами высокого риска, когда возможность излечения антибиотиками маловероятна.
Инфекционный эндокардит (ИЭ) — нередкое угрожающее жизни заболевание сердца, ежегодная заболеваемость которым составляет 3,8 случая на 100 тыс. населения [1]. Современное понимание этиологии этого заболевания включает не только бактерии (грамположительная и грамотрицательная флора), но и дрожжевые и плесневые грибы — кандидозный и аспергилезный эндокардит [1], риккетсии и хламидии [2]. В структуре современного ИЭ велика роль так называемой культуронегативной формы [3].
Известно, что раннее выявление (до 2 мес) заболевания и правильная интерпретация клинических данных служит оптимизации сроков хирургического вмешательства и лучшим ближайшим и отдаленным результатам.
Цель настоящего исследования — оценка значимости комплексной эхокардиографии (ЭхоКГ) в своевременной и полноценной диагностике ИЭ и результатов консервативной и хирургической тактики лечения.
Материал и методы
За период с 1978 по 2013 г. наблюдались 458 пациентов с клапанным ИЭ в возрасте от 12 до 75 лет (средний возраст 49,0±9,3 года, 69,1% мужчин), что составило 13% от всех оперированных больных клапанными пороками сердца. Хроническая сердечная недостаточность (СН) IV функционального класса по классификации Нью-Йоркской ассоциации сердца имелась у 307 (67%) пациентов, III — у 114 (24,9%), II — у 37 (8,1%).
ИЭ возник на фоне исходного ревматического поражения клапанного аппарата сердца в 190 (41,5%) наблюдениях (из них инфекционное поражение протезированных клапанов у 37 пациентов), врожденной аномалии клапанного аппарата (системные дегенеративные заболевания соединительной ткани, двустворчатый аортальный клапан — АК) — в 174 (37,9%), без предшествующей патологии — в 95 (20,6%) случаях.
Активная фаза инфекционного процесса отмечена в 219 (47,8%) наблюдениях, ремиссия — в 239 (52,2%). Внутрисердечное абсцедирование было диагностировано у 23 (5%) больных.
Положительная гемокультура до операции получена у 66% пациентов, наиболее часто возбудителями ИЭ в нашем исследовании были стафилококки различных типов — 72%.
У 34% пациентов имелась культуронегативная форма ИЭ.
Непосредственные причины, приведшие к возникновению ИЭ, были выявлены только у 58% пациентов. При этом главными причинами в общей структуре были простудные заболевания верхних дыхательных путей (26%) и одонтогенный ИЭ (21%).
Обследование больных, поступавших в клинику с подозрением на ИЭ, проводилось по традиционному плану, включавшему клинический, лабораторный и инструментальный методы исследования и исключавшему инвазивные предоперационные исследования.

Показаниями к хирургическому лечению служили прогрессирующая СН (III—IV стадии по классификации А.Н. Бакулева и Е.А. Дамир), возможность первичного или повторного возникновения эмболического синдрома, перианулярное абсцедирование, отсутствие эффекта от антибиотикотерапии [3]. В активной фазе ИЭ были оперированы 53% пациентов, в стадии ремиссии — 47% .
Изолированное поражение АК отмечено у 212 (46,4%) пациентов, митрального клапана (МК) — у 156 (34,2%), трикуспидального клапана (ТК) — у 15 (3,3%). Наиболее тяжелую группу составили пациенты с комбинированным поражением клапанов (2 и более) — МК и АК — 69 (15,2%), АК и ТК — 3 (0,6%), а также МК, АК и ТК — 3 (0,6%). Ранний рецидив ИЭ (в срок до 6 мес) наблюдался в 10,7%, поздний — в 16,1% случаев [3].
Все пациенты были оперированы. Целью операции было не только восстановление нормальной гемодинамики, но и надежная санация очага внутрисердечной инфекции. Объем хирургического вмешательства представлен в таблице.
Комплексная ЭхоКГ включала трансторакальную ЭхоКГ (ТТ-ЭхоКГ), выполненную на приборах SSD-870, 2000, 5500, Sequoja-256, iE 33 с использованием датчиков с частотой 2,4—3,5 МГц, и чреспищеводную ЭхоКГ (ЧП-ЭхоКГ), выполненную на приборах Sonos-1500, 12810M/ XP с применением эндоскопического омнипланового датчика с частотой 5 МГц. Оба вида исследований базировались на одномерной, двухмерной и допплер-ЭхоКГ, включавших импульсноволновую, постоянноволновую, цветовую и тканевую методики. Более высокая частота эндоскопического датчика, отсутствие помех от легких, ребер и жира позволяли получить изображение структур сердца при ЧП-ЭхоКГ более высокого качества, чем при ТТ-ЭхоКГ.
Результаты всех ЭхоКГ верифицировали при непосредственной интраоперационной ревизии с последующим гистологическим исследованием удаленного клапана.
Результаты и обсуждение
Морфологически ИЭ представляет собой воспалительно-деструктивные изменения клапанов и подклапанных структур с формированием вегетаций, воспалительное поражение магистральных сосудов, тромбоэмболические и иммунопатологические изменения в органах и тканях.
Более четверти века усилия ученых мира [4] направлены на неинвазивные (с помощью сначала одномерной, а затем и двухмерной ЭхоКГ) поиски «большого критерия» ИЭ по диагностической схеме Университета Duke в США [5] — так называемых вегетаций (инфицированных тромботических масс) на эндокардиальной поверхности сердца.
При ИЭ чаще всего.
Кузнецова Л.М. , Сандриков В.А. , Иванов В.А. , Домнин В.В. , Ярыгин И.В. , Буравихина Т.А. , Евсеев Е.П. , Кипренский А.Ю.
Инфекционный эндокардит
Внутрисосудистая инфекция сердечно-сосудистых структур (клапанов, эндокарда предсердий и желудочков), включая эндартериит крупных внутригрудных сосудов, или внутрисердечных инородных тел (искусственных клапанов, электродов кардиостимулятора), соприкасающихся с кровотоком (ESC).
• Преходящая бактериемия (кожа, ротовая полость, желудочнокишечный тракт).
• Микробы, склонные к адгезии на поврежденный эндотелий.
• Повреждение/воспаление эндотелия.
• Образование микробами биопленки, защищающей от иммунной системы и антибиотиков.

Инфекционного эндокардита
• Ревматическая болезнь сердца.
• Врожденные (цианотичные) пороки сердца.
• Искусственные клапаны сердца.
• Гемодиализ.
• Венозные катетеры.
• Внутривенное введение препаратов.
• Иммунодепрессанты.
• Пожилой и старческий возраст.
Тромбоэмболий
• Вегетации >10 мм (Mohananey D, et al, 2018).
• Флотирующие вегетации.
• Поражение митрального клапана.
• Инфекция Staph. aureus.

БОЛЬШИЕ КРИТЕРИИ
1. Положительная культура крови
1.1. Типичные микробы в 2 пробах крови:
• Str. viridans, Str. gallolyticus (bovis), Staph. aureus, HACEK группа.
• Внебольничные Enterococci без первичного очага.
1.2. Повторные культуры крови, характерные для ИЭ:
• ≥2 культур крови с интервалом >12 ч.
• Все 3 культуры крови или большинство из ≥4 проб.
1.3. Культура Coxiella burnetti или IgG в титре >1:800.
2. Визуальные признаки
2.1. Эхокардиографические признаки:
• Вегетация,
• Абсцесс, псевдоаневризма, интракардиальная фистула.
• Перфорация или аневризма клапана.
• Новое частичное раскрытие искусственного клапана.
2.2. Аномальная активность возле искусственного клапана по 18Ф-ФДГ ПЭТ/КТ (имплантация >3 мес) или СПЕКТ/КТ сцинтиграфии с меченными лейкоцитами.
2.3. Паравальвулярное повреждение по КТ сердца.
МАЛЫЕ КРИТЕРИИ
1. Предрасполагающие заболевания сердца, инъекции.
2. Лихорадка >38°С.
3. Сосудистые феномены: эмболии крупных артерий, септические инфаркты легких, микотические аневризмы, внутричерепные кровоизлияния, кровоизлияния в конъюнктиву, повреждения Джейуэя.
4. Иммунные нарушения: гломерулонефрит, узелки Ослера, пятна Рота, ревматоидный фактор.
5. Культура крови, не соответствующая большим критериям, или серологические признаки активной инфекции микробом, способным вызвать ИЭ.
Определенный ИЭ = 2 больших, или 1 большой + 3 малых, или 5 малых.
Вероятный ИЭ = 1 большой + 1 малый или 3 малых.
• Посевы крови: тест ускоренной оценки бактеремии (Verigene Blood Culture Test).
• Полимеразная цепная реакция крови: Staph. aureus, Tropheryma whipplei, Fungi, E. coli, Strept. gallolyticus, Streptococcus mitis, Enterococci.
• Консультация стоматолога.
• Трансторакальная эхокардиография.
• Чреспищеводная эхокардиография: подозрение на ИЭ при нормальном трансторакальном исследовании, повторно через 5–7 дней после первого исследования если клинически сильные подозрения на ИЭ.
• Компьютерная томография сердца: искусственные клапаны, паравальвулярные осложнения.
• Компьютерная томография, магнитно-резонансная томография головы (инсульты в 20–40%), внутренних органов: тромбоэмболии, геморрагии.
• Колоноскопия (Str. gallolyticus).

Локализация
• Естественные клапаны.
• Искусственные клапаны: ранний [ • Искусственные устройства: кардиостимулятор, имплантируемый дефибриллятор.
• Левосторонний, правосторонний.
Этиология
• Oral streptococci (viridans).
• Staphylococcus aureus, коагулазонегативные staphylococci.
• Enterococci, HASEK группа, грибы, культурально-негативный.
Условия заболевания
• Нозокомиальный: симптомы >48 ч госпитализации.
• Ненозокомиальный: симптомы • Внебольничный: симптомы • Ассоциированный с наркотиками: у пациента, потребляющего наркотики в/в, при отсутствии других источников инфекции.
Диагностика
• Определенный (по критериям Дюке).
• Вероятный.
Активность
• Персистирующая лихорадка и положительная культура.
• Лечение антибиотиками.
• Морфологические признаки воспаления при хирургии.
• Гистологические признаки активного ИЭ.
Течение
• Первый эпизод.
• Рецидивирующий: тот же микроб, • Повторный: другой микроб, >6 мес после эпизода.

ЭхоКГ — эхокардиография, ЧПЭхоКГ — чреспищеводная эхокардиография.
Habets J, et al. Europ Radio. 2015;25:2125–33.
□ Инфекционный эндокардит митрального клапана с умеренной регургитацией и лабильной вегетацией (2х0.5 см), активный. Фибрилляция предсердий. ХСН II ФК. [I33.0]
□ Инфекционный эндокардит аортального клапана с тяжелой регургитацией, излеченный, ХСН III ФК, 2Б. Инфаркт миокарда (2014), инфаркт правой почки (2018). [I33.0]
□ Инфекционный эндокардит искусственного аортального клапана, активный, поздний. Желудочное кровотечение (варфарин, 12.04.2020). [I33.0]
□ Инфекционный эндокардит трехстворчатого клапана с умеренной недостаточностью, повторный. Острая сердечная недостаточность. Рецидивирующая легочная эмболия, пневмония. [I33.0]
□ Инфекционный эндокардит трехстворчатого клапана с выраженной регургитацией, ассоциированный с наркотиками, активный. Сердечная недостаточность, декомпенсация. [I33.0]

• Мультидисциплинарная команда.
• Антибактериальная программа.
• Хирургия (50–60%): удаление инфицированных тканей, инородных материалов, очистка и дренирование паравальвулярной инфекции, удаление источника эмболии, реконструкция клапана, замена клапана.
• Профилактика: гигиена рта, антибиотики перед стоматологическими вмешательствами при очень высоком риске, уход за в/в катетерами, обучение и замена игл у наркоманов.

Лечение острого ИЭ до выявления микроба
• Ампициллин + Оксациллин по 12 г/сут в 4 приема в/в + Гентамицин 3 мг/кг однократно в/в, в/м.
• Ванкомицин 30 мг/кг/сут в 2 приема в/в + Гентамицин 3 мг/кг однократно в/в, в/м.
• Ванкомицин 30 мг/кг/сут в 2 приема в/в + Гентамицин 3 мг/кг однократно в/в, в/м + Рифампин 900–1200 мг в 2 приема в/в, per os при нозокомиальном или раннем эндокардите искусственного клапана.
Стрептококк, чувствительный к пенициллину
• Цефтриаксон 2 г однократно или Амоксициллин 100–200 мг/кг/сут в 4 приема в/в [4 нед].
• Цефтриаксон 2 г однократно или Амоксициллин 100–200 мг/кг/сут в 4 приема в/в + Гентамицин 3 мг/кг однократно в/в, в/м [2 нед].
• Ванкомицин 30 мг/кг/сут в 2 приема в/в [4 нед].
Стрептококк, относительно нечувствительный к пенициллину
• Цефтриаксон 2 г однократно или Амоксициллин 200 мг/кг/сут в 4 приема в/в [4 нед] + Гентамицин 3 мг/кг однократно в/в, в/м [2 нед].
• Ванкомицин 30 мг/кг/сут в 2 приема в/в [4 нед] + Гентамицин 3 мг/кг однократно в/в, в/м [2 нед].
• Терапия 6 вместо 4 нед при эндокардите искусственного клапана.
Стафилококк, чувствительный к метициллину
• Оксациллин 12 г/сут в 4 приема в/в [4–6 нед].
• Оксациллин 12 г/сут в 4 приема в/в + Рифампин 900–1200 мг в 2 приема в/в, per os [≥6 нед] + Гентамицин 3 мг/кг однократно в/в, в/м [2 нед] при искусственном клапане.
Стафилококк, нечувствительный к метициллину
• Ванкомицин 30–60 мг/кг/сут в 2 приема в/в [4–6 нед].
• Даптомицин 10 мг/кг однократно в/в [4–6 нед].
• Ванкомицин 30–60 мг/кг/сут в 2 приема в/в + Рифампин 900–1200 мг в 2 приема в/в, per os [≥6 нед] + Гентамицин 3 мг/кг однократно в/в, в/м [2 нед] при искусственном клапане.
Проводится парентерально через 2 нед госпитального лечения.
• Сердечная недостаточность.
• Сложная инфекция.
• Высокий риск эмболии.
• Неврологические осложнения.
• Дисфункция почек.
Сердечная недостаточность
• Выраженная регургитация или обструкция с симптомами СН или эхокардиографическими признаками нарушенной гемодинамики.
• Отек легких или кардиогенный шок.
Неконтролируемая инфекция
• Локальная: абсцесс, ложная аневризма, фистула, растущие вегетации.
• Инфекция грибами или мультирезистентными микроорганизмами.
• Персистирующая позитивная культура крови, несмотря на адекватную антибиотикотерапию и контроль септических метастатических очагов.
• Эндокардит искусственных клапанов, вызванный стафилококками или не-HACEK грамотрицательными бактериями.
Профилактика эмболий
• Эндокардит аортального или митрального клапанов с персистирующими вегетациями >10 мм после ≥1 эмболического эпизода, несмотря на адекватную антибиотикотерапию.
• Эндокардит аортального или митрального клапанов с изолированными вегетациями >30 мм.
• Искусственные клапаны и материалы: искусственный клапан, транскатетерная имплантация клапана, восстановление клапана (кольца для аннулопластики, клипсы), искусственный помощник левого желудочка, имплантированное сердце.
• Предшествующий эпизод инфекционного эндокардита.
• Врожденная болезнь сердца: некорригированные цианотичные болезни, исправление дефекта с помощью искусственных материалов или устройств в течение 6 мес до процедуры, коррекция с остаточным дефектом, прилегающим к искусственной заплате или устройству.
• Сердечный трансплантант с развившейся вальвулопатией.

За 30–60 мин до стоматологического вмешательства с вовлечением десны, периапикальной области или с повреждением слизистой рта:
• Амоксициллин 2 г per os.
• Ампициллин 2 г в/м или в/в.
В случае аллергии на пенициллины:
• Азитромицин 500 мг per os.
• Цефалексин 2 г per os.
• Цефазолин 1 г в/м или в/в.
• Цефтриаксон 1 г в/м или в/в.
Статьи
Трансторакальная эхокардиография (обычное исследование, при котором датчик находится на поверхности грудной клетки), безусловно, достигла больших успехов. Однако в ряде случаев ее проведению мешают акустические препятствия на пути ультразвукового луча, которые локализуются вне сердца (ребра, легкие, мышцы, подкожно-жировая клетчатка) или в самом сердце (протезированные клапаны, кальциноз). Использование чреспищеводного (трансэзофагиального) ультразвукового доступа позволяет преодолеть все эти трудности: пищевод непосредственно прилежит к левому предсердию (расположенному кпереди от пищевода) и нисходящему отделу аорты (расположенному кзади от пищевода). Метод, позволяющий увидеть то, чего нельзя увидеть при трансторакальной эхокардиографии – чреспищеводная эхокардиография.
Этот метод исследования дает максимальное разрешение при визуализации структур сердца. В частности, только методом чреспищеводной эхокардиографии можно выявить наличие тромбов в ушках предсердий. Значительно лучше, чем при трансторакальном исследовании, при чреспищеводной эхокардиографии обнаруживаются образования в камерах сердца (тромб, опухоль), детально описываются их размеры, конфигурация, место прикрепления. Чреспищеводная эхокардиография является лучшим методом для обнаружения и описания вегетаций на створках клапанов сердца (разрастаний, которые бывают при некоторых заболеваниях), врожденных и приобретенных пороков сердца, состояния протезов сердечных клапанов. Поэтому чреспищеводная эхокардиография получает все большее клиническое применение для распознавания опухолей и тромбов в предсердиях, патологии протезированных клапанов, инфекционного эндокардита, болезней аорты, врожденных пороков сердца, а также для интраоперационного (во время операции) мониторинга функции левого желудочка.
Чреспищеводное исследование не так легко выполнимо технически, как трансторакальное, поэтому его проведению всегда должно предшествовать тщательное трансторакальное исследование сердца и обследование пищевода.
В Центре им. Н. А. Семашко данное исследование проводится на современном ультразвуковом сканере Aloka SSD 5500 (Япония) при помощи современного трансэзофагиального датчика.
Показания к чреспищеводной эхокардиографии
- Подозрение на абсцесс корня аорты, клапанных колец, парапротезную фистулу при инфекционном эндокардите
- Подозрение на дисфункцию протезированного клапана (особенно в митральной позиции)
- Исследование митрального клапана перед реконструктивной операцией, вальвулопластикой и после них
- Исследование структур, удаленных от передней грудной стенки
- Подозрение на расслаивающую аневризму аорты
- Подозрение на тромбы левого предсердия
- Поиск источника эмболии артерий большого круга кровообращения
- Подозрение на инфекционный эндокардит в отсутствие вегетаций при трансторакальной ЭхоКГ
- Низкая нформативность трансторакальной ЭхоКГ
Подготовка к исследованию.
В течение 4-6 часов перед исследованием пациент не должен есть, пить и курить. Съемные зубные протезы должны быть удалены.
Относительными противопоказаниями к исследованию являются заболевания пищевода: злокачественные новообразования, дивертикул пищевода, фистулы, стриктуры, варикозное расширение вен пищевода, воспалительные заболевания пищевода, кровотечение из верхней части желудочно-кишечного тракта.
Техника проведения исследования
Введение датчика в пищевод проводится врачом-эндоскопистом. Для уменьшения рвотного рефлекса производят поверхностную анестезию глотки (аэрозоль Лидокаина 10%). При интубации пищевода пациента лежит на левом боку.
Общее время нахождения датчика в пищеводе обычно не превышает 7-12 минут.
При гастроскопии (ФГДС) вероятность перфорации пищевода менее одного случая на три тысячи исследований. При чреспищеводной эхокардиографии она еще меньше, так как исследованию не подвергают пациентов с какой-либо патологией пищевода. К другим нечастым осложнениям чреспищеводной эхокардиографии относятся нарушения ритма сердца, сосудистые реакции (например, снижение АД).
Адрес: 163000, г. Архангельск, пр. Троицкий 115 | 163000, г. Архангельск, наб. Сев. Двины 66 | 163020, г. Архангельск, ул. Адмиралтейская 2
Читайте также:


